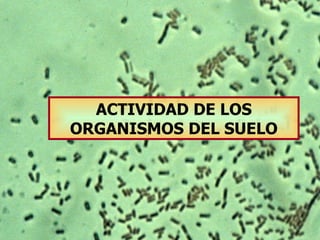
ACTIVIDAD DE LOS ORGANISMOS DEL SUELO

El documento describe la composición biológica del suelo y las redes alimentarias que existen. Explica que el suelo contiene bacterias, hongos, algas y fauna que desempeñan funciones como la formación del suelo, el crecimiento de las plantas y el ciclo del carbono. También describe los diferentes hábitats de los microorganismos del suelo como la rizosfera, agregatusfera y detritusfera.